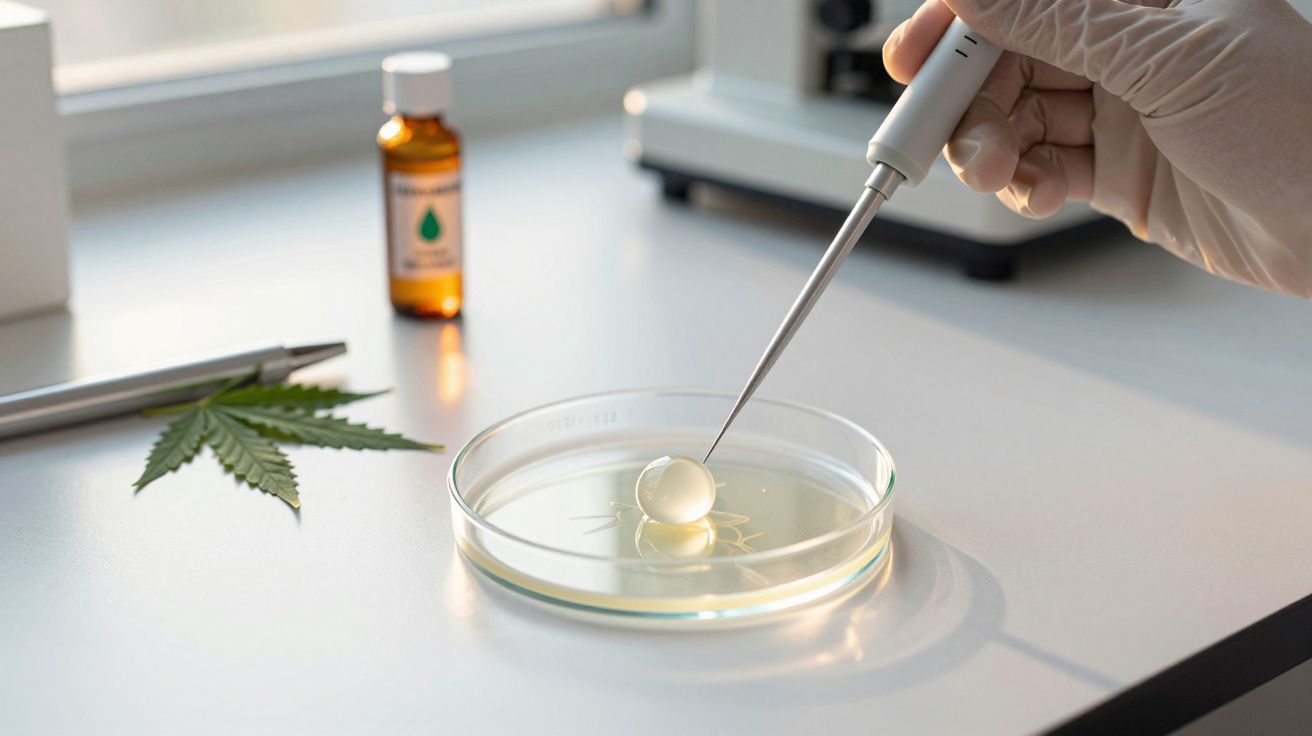
Mão com luva a manipular bolha em placa de Petri numa bancada com folha de planta e frasco ao fundo.

Um novo estudo alerta que níveis elevados de consumo de cannabis podem reduzir as hipóteses de engravidar através de fertilização in vitro (FIV).
Cannabis e FIV: o que revela o THC no líquido folicular
Ao analisarem 1.059 amostras de líquido folicular - o fluido que envolve os óvulos em desenvolvimento - de pessoas submetidas a tratamentos de FIV, a embriologista Cyntia Duval, da Universidade de Toronto, e a sua equipa identificaram 62 amostras positivas para tetrahidrocanabinol (THC).
Os oócitos (células-ovo imaturas) provenientes de líquidos foliculares com maiores concentrações de THC apresentaram maior probabilidade de anomalias cromossómicas. Além disso, estes oócitos tenderam a maturar mais depressa do que os controlos correspondentes, nos quais não foi detetado THC no líquido folicular.
O que os resultados sugerem (e o que não avaliam)
Segundo o farmacologista Mark Connor, da Universidade Macquarie, que não participou no trabalho, os dados indicam que o consumo de cannabis pode influenciar o desfecho da FIV.
Ao mesmo tempo, o investigador sublinha que este estudo não avaliou os possíveis efeitos do consumo de cannabis na conceção natural.
Ensaios adicionais com óvulos: mais erros cromossómicos e maturação acelerada
Numa etapa seguinte, a equipa de Duval testou óvulos de 24 participantes que deram consentimento. Estas experiências reforçaram o padrão observado: óvulos não fertilizados expostos a concentrações de THC acima da média registada no ensaio anterior mostraram quase mais 10% de erros cromossómicos e voltaram a evidenciar maturação mais rápida.
Os autores assinalam, no entanto, que a amostra é reduzida, o que impede controlar devidamente outros fatores relevantes para a fertilidade - como a idade. Atualmente, a idade é o principal fator de risco associado a uma redução da qualidade dos óvulos.
Euploidia embrionária, implantação e risco de falha da FIV
Para o obstetra-ginecologista Alex Polyakov, da Universidade de Melbourne, também não envolvido na investigação, os resultados apontam para um impacto específico: o consumo de cannabis poderá comprometer os resultados reprodutivos não por impedir a fertilização, mas por diminuir a probabilidade de obter embriões cromossomicamente normais.
Como a euploidia embrionária está intimamente ligada ao sucesso da implantação e a uma gravidez saudável, a exposição à cannabis poderá prolongar o tempo até à conceção e aumentar o risco de insucesso da FIV e de aborto espontâneo.
Evidência noutras linhas de investigação e preocupações de saúde
Estudos em animais já tinham mostrado que a exposição ao THC pode prejudicar o desenvolvimento embrionário. Em humanos, outras investigações encontraram associações moderadas entre consumo regular de cannabis e infertilidade, o que reforça a necessidade de mais estudos.
Embora a utilização de cannabis - médica e recreativa - esteja a proporcionar alívio da dor e apoio na saúde mental a um número crescente de pessoas, continua a estar associada a riscos importantes, incluindo perda de memória de trabalho e aumento do risco de doença cardíaca.
O consumo durante a gravidez não é recomendado e, na ausência de evidência mais robusta, abster-se durante a fase de conceção é a opção mais prudente.
Recomendações práticas para quem está a tentar engravidar
Trabalhos anteriores também relacionaram o consumo de cannabis com problemas no esperma. Por isso, vários especialistas apoiam orientações que recomendam evitar adicionar cannabis à lista de substâncias que potenciais mães e pais devem evitar ao tentar engravidar, durante a gravidez e na amamentação.
Num estudo de 2021, a obstetra Kimberly Ryan, da Universidade de Saúde e Ciência do Oregon, e colegas defendem que, até ao momento, não existe um nível de consumo de cannabis durante a conceção ou a gravidez que se saiba ser bem tolerado; com a evidência limitada disponível, a escolha mais segura é a abstinência.
De forma prática, quem está a iniciar ou já se encontra em FIV deve discutir abertamente o consumo de cannabis com a equipa clínica. A decisão pode exigir ponderação individual (frequência, dose, via de consumo e outros fatores de saúde), mas a transparência ajuda a definir um plano mais seguro e alinhado com os objetivos do tratamento.
Importa ainda ter em conta que o THC pode permanecer no organismo durante algum tempo, sobretudo em consumidores frequentes, o que torna relevante planear a interrupção com antecedência. Além da cannabis, clínicas de fertilidade costumam recomendar reduzir ou evitar outros fatores que podem afetar a qualidade dos gâmetas e do embrião, como álcool, tabaco e privação de sono, integrando estas medidas numa estratégia global de otimização da fertilidade.
A nova investigação foi publicada na revista Comunicações da Natureza.

Comentários
Ainda não há comentários. Seja o primeiro!
Deixar um comentário